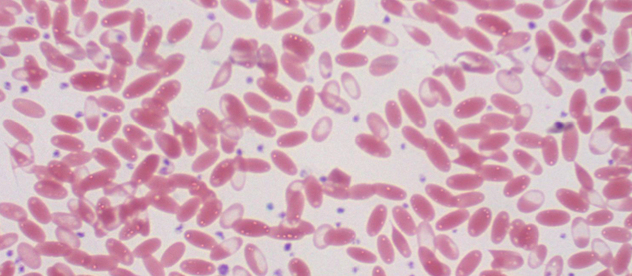
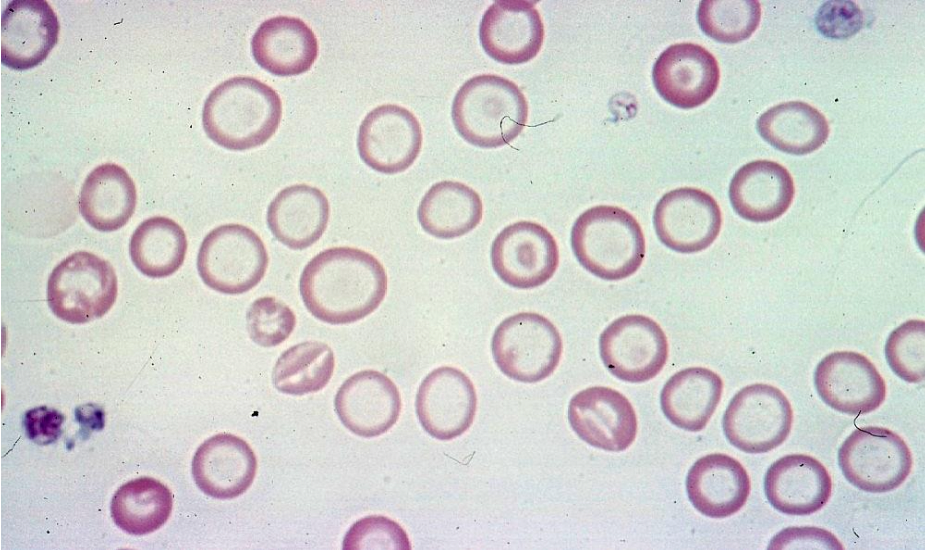
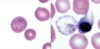
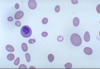
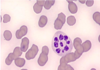

Nommer les 6 principaux types d’anémies non-régénératives.
- Anémie par déficience en fer
- Anémie de condition inflammatoire
- Anémie associée à la maladie rénale
- Anémie associée à une déficience hormonale
- Anémie associée à l’hyperoestrogénisme
- Maladies de moelle osseuse
Nommer l’espèce chez laquelle on retrove des globules rouges de cette forme.
Des alpagas
Quelle type d’anémie est la plus commune en médecine vétérinaire?
Anémies non-regénératives
Nommer les deux causes principales d’une anémie non-régénérative.
- Diminution de l’érythropoïèse
- Érythropoïèse inefficace
Nommer 3 causes d’une diminution de l’érythropoïèse.
- Anémie d’inflammation
- Maladie rénale
- Maladie chronique
Nommer 3 causes d’une érythropoïèse inefficace.
- Déficience en vit. B12, folate, Fe
- Destruction des précurseurs
- Myélodysplasie
Quand est-ce qu’on peut observé une anémie par déficience en fer? (2)
- Jeunes (manque d’apport ou parasites)
- Adultes (pertes chroniques de sang a/n GI ou saignements internes)
Anémie légère à sévère
Anémie légère à sévère, PEU FRÉQUENT!
Expliquer l’étiologie et la pathogénèse d’une anémie par déficience en fer.
La synthèse d’Hg est diminuée ce qui augmente le nombre de divisions cellulaires pour essayé de comblé les besoins.
–>Une anémie par déficience en fer devient microcytaire + hypochrome
Nommer les 3 changements de laboratoires possibles lors d’une anémie par déficience en fer.
- Habituellement non régénérative mais parfois légèrement régénérative
–>En fonction de l’étiologie: manque d’apport vs pertes chroniques de sang - Poïkilocytose possible (GRs de forme anormale)
- Thombocytose possible
Nommer le type d’anémie présent
Anémie par déficience en fer
Cellules sont hypochromes!
Comment est-ce qu’on peut confirmer une anémie par déficience en fer?
Indices de fer:
1. diminution du fer serique
2. Augmentation de la capacité de liaison de la transferrine
3. Diminution de la ferritine sérique
4. Diminution de la % de saturation en fer
5. Augmentation de la transferrine
6. Diminution des réserves de fer dans la moelle osseuse

Est-ce que la diminution du fer sérique est une bonne paramètre pour diagnostiqué une anémie par déficience en fer? (2)
- Pas vraiment spécifique, également notée lors d’anémie de condition inflammatoire
- Chez le chien et le cheval, il a été démontré que l’administration de glucocorticoïdes entraîne une** fausse ⬆️ de la valeur sérique du fer**
Est-ce que l’augmentation de la capacité de liaison de la transferrine (TIBC) est une bonne paramètre pour diagnostiqué une anémie par déficience en fer? (2)
–>Mesure indirecte de la transferrine
* Habituellement, le TIBC est normal lors de déficience en fer chez le chien et le chat, mais est augmenté chez les ruminants, chevaux et porcs
Comment est-ce qu’on mesure une augmentation de la capacité de liaison de la transferrine (TIBC)?
- Ajout de fer au sérum (pour saturer le transferrin)
–>Dosage (UIBC: unbound IBC) - Fer lié artificiellement (UIBC) + Fer total = TIBC
–>Lors de déficience en fer UIBC augmente, donc TIBC augmente
Comment est-ce qu’on calcule une diminution du % de saturation en fer?
Fer sérique/TIBC
Quel paramètre nous permet de différencier l’anémie de condition inflammatoire de l’anémie par déficience en fer?
Une diminution de la ferritine sérique
Disponible pour le chien, le chat et le cheval.
Voici deux échantillons de la moelle osseuse. Laquelle des deux est normal?

Fer coloré en mauve

Nommer les 4 principaux charactéristiques d’une anémie de condition inflammatoire.
- Très commune
- Causée par un processus inflammatoire
–>Infectieux, néoplasique… - Anémie légère à modérée
- Anémie souvent sous clinique
Expliquer les 3 possibilités causes d’une anémie de condition inflammatoire.
- Dérégulation de l’homéostasie du fer
- Diminution de la prolifération des cellules souches érythroïdes
- Réponse diminuée à l’érythropoïétine
Expliquer la pathogénie de la dérégulation de l’homéostasie du fer qui cause une anémie de condition inflammatoire
Mécanisme évolutif qui protège l’individu lors d’un foyer inflammatoire.
–>L’hepcidine est produit par les hépatocytes lors d’un foyer inflammatoire (rôle: régulateur du métabolisme du fer, dégrade la ferroportine qui est responsable du transport du fer)
–> Ce mécanisme favorise la séquestration du fer dans les macrophages et les hépatocytes et inhibe l’absorption du fer au niveau intestinal

Nommer les 3 signes cliniques (résultats de labo) observées lors d’une anémie de condition inflammatoire.
- Changements hématologiques:
–>Anémie légère à modérée
–>Normocytaire normochrome NR
–>Aucune évidence de pathologies de GR - Diminution du fer sérique
–>Augmentation des réserves de fer (ferritine, hémosidérine) - Évidence d’une inflammation
–>Changements a/n des GB, trouvailles cliniques, etc.
Nommer le type d’anémie qui est la 2ième cause la plus fréquente en med vet.
Anémie associée à la maladie rénale
Signes associés principalement à la maladie rénale
Vrai ou faux: une anémie associée à la maladie rénale peut être sévère et régénérative
Faux, peut être sévère, non régénérative
Nommer les 4 origines possibles d’une anémie associée à la maladie rénale
- Diminution de la production d’érythropoïétine (EPO)
- Demi-vie des GR plus courte
- Possibles saignements (urémie)
- Condition inflammatoire concomitante